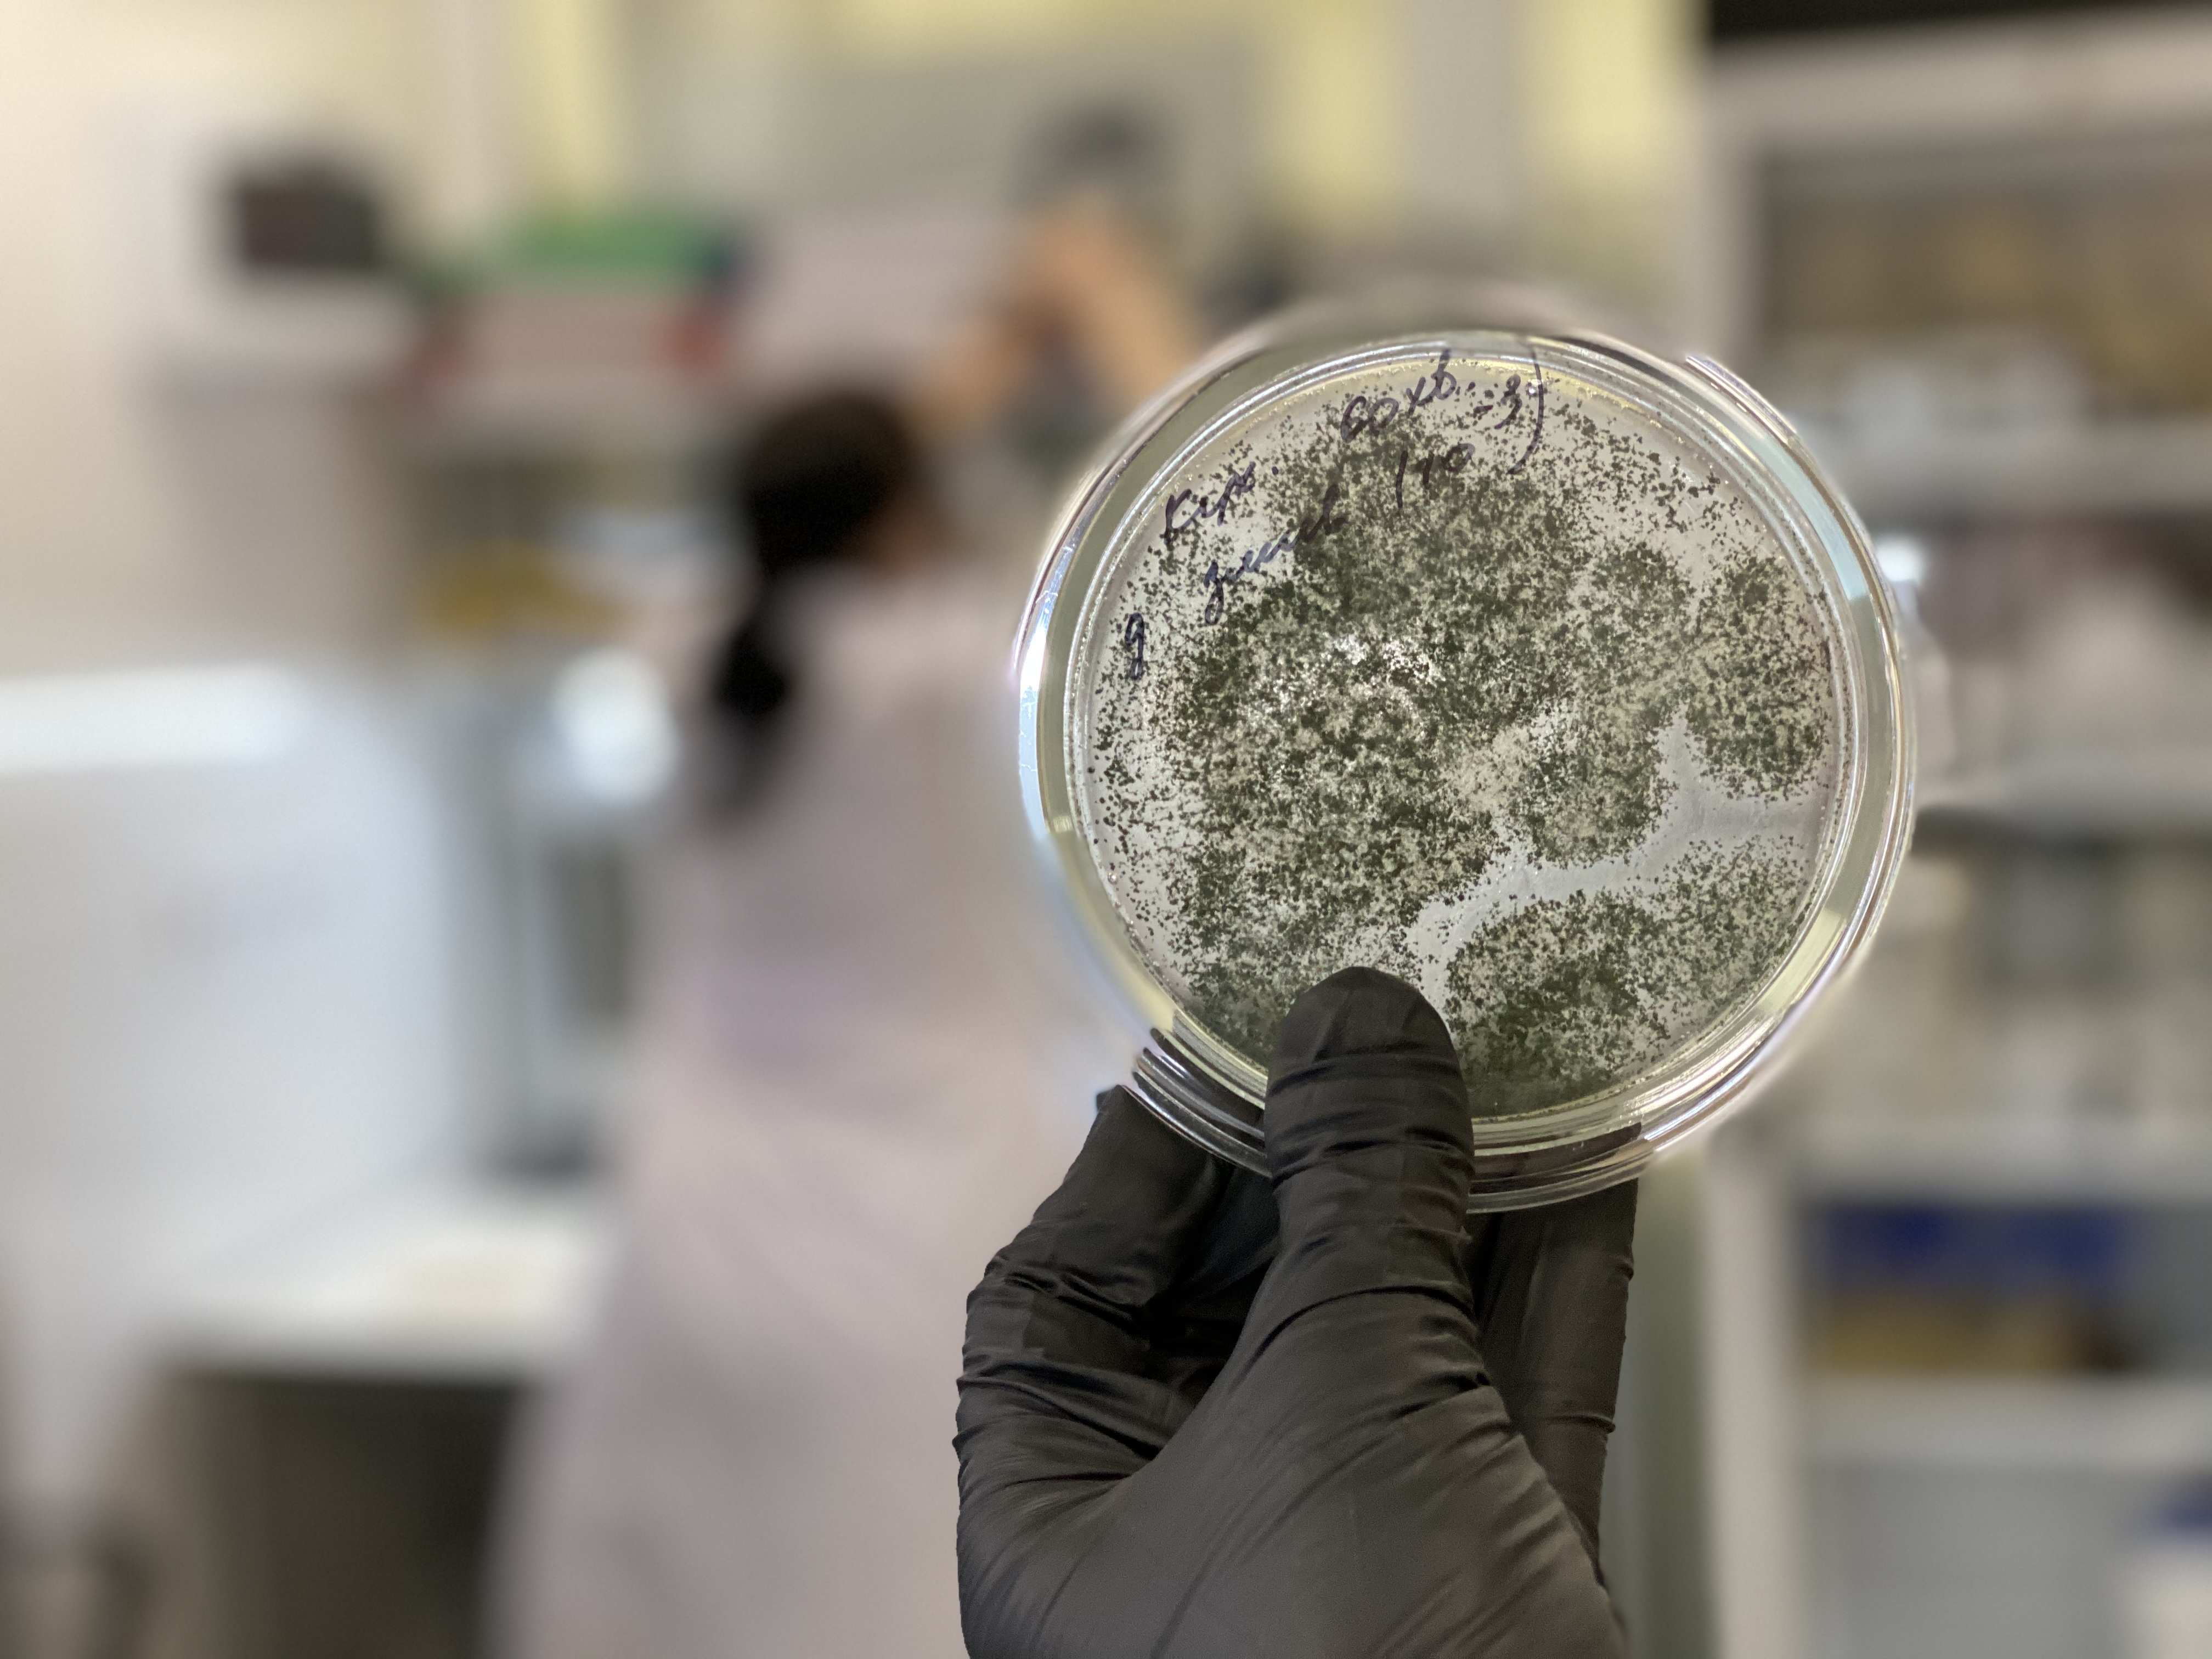

R&D
Healthy Land biological preparations are produced at the BTU-Center plant in Ukraine.
For more than 25 years, BTU-CENTER has been engaged in the development, production and sale of effective biological preparations for growing healthy crops.
We ensure a high level and control at all stages of production, from laboratories to shelves of garden and store chains.
The production capacity of the company plant is 10,000 tons of products per year. The products are used by millions of farmers and gardeners around the world.

LABORATORY
There is a certified laboratory at the production base where microbiologists, biochemists and scientists with more than 40-year experience in the industry work.
To create our products we use our own microorganism strain bank, from which active strains isolated from natural sources are carefully selected.
ABOUT BACTERIA
Our preparations contain natural beneficial microorganisms that provide balanced plant nutrition and restore soil fertility:
Bacillus subtilis is bacteria capable of producing enzymes for the decomposition of complex organic molecules in the soil.
They provide nitrogen fixation, mobilize phosphorus and potassium from poorly soluble compounds.
Enterobacter is bacteria capable of producing enzymes for the decomposition of complex organic soil molecules, nitrogen fixation, phosphorus and potassium mobilization.
Enterococcus is lactic acid bacteria that stimulate plant development.
Trichoderma lignorum, Trichoderma viride is fungi that actively colonize and decompose plant remains and promote the development of the root system.
Azotobacter Chroococcum is free-living bacteria that fix molecular nitrogen in the atmosphere and convert it into a form available to plants.
Lactobacillus is a group of microorganisms that have the ability to form a protein film on the surface of plants, ensuring their stress resistance to negative factors and protecting the plant from the penetration of harmful microorganisms.
Paenibacillus Polymyxa is aerobic bacteria that produce phosphatase, ensuring the availability of mineral and organic soil phosphates for plants. They have a positive effect on the structure of the soil, its aeration and moisture supply.